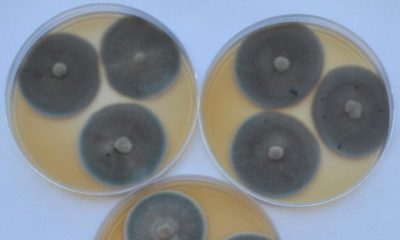
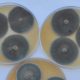

Pesquisadores da Universidade Federal de Santa Maria (UFSM) descobriram no município de São João do Polêsine, no Rio Grande do Sul, um fóssil que faz parte...


Biblioteca do Vaticano O texto bíblico apareceu quando foi iluminado por luz ultravioleta entre as páginas de um pergaminho Uma equipe de pesquisadores descobriu um suposto...

Um grupo de pesquisadores de Mato Grosso descobriu e identificou uma nova espécie de fungo endofítico no bioma do Pantanal mato-grossense capaz de ajudar a descontaminar...